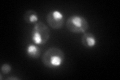
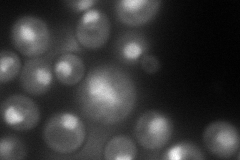
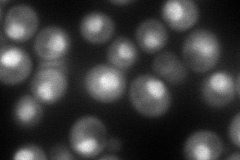
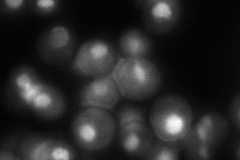
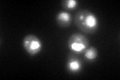
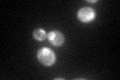

View description
Subunit of the 19S regulatory particle of the 26S proteasome lid; synthetically lethal with RPT1, which is an ATPase component of the 19S regulatory particle; physically interacts with Nob1p and Rpn3p
Localization:
Intensity:
Fold change:
Significance:
-
C’ GFP library in SD
nucleus123.38 -
N' NOP1pr-GFP in SD
nucleolus140.925 -
N' TEF2pr-mCherry in SD
nucleus115.667 -
N' NATIVEpr-GFP in SD
nucleus109.006 -
N' TEF2pr-VC and Cyto-VN in SD

nucleus53.9636 -
C’ GFP library in SD+DTT
nucleus140.021.13No -
C’ GFP library in SD+H2O2

nucleus143.231.16No -
C’ GFP library in Starvation Media
nucleus138.911.12No -
C’ GFP library on the background of Pup2-DaMP

nucleus -
C’ GFP library on the background of CCT mutant

nucleus147.7271.19723No
